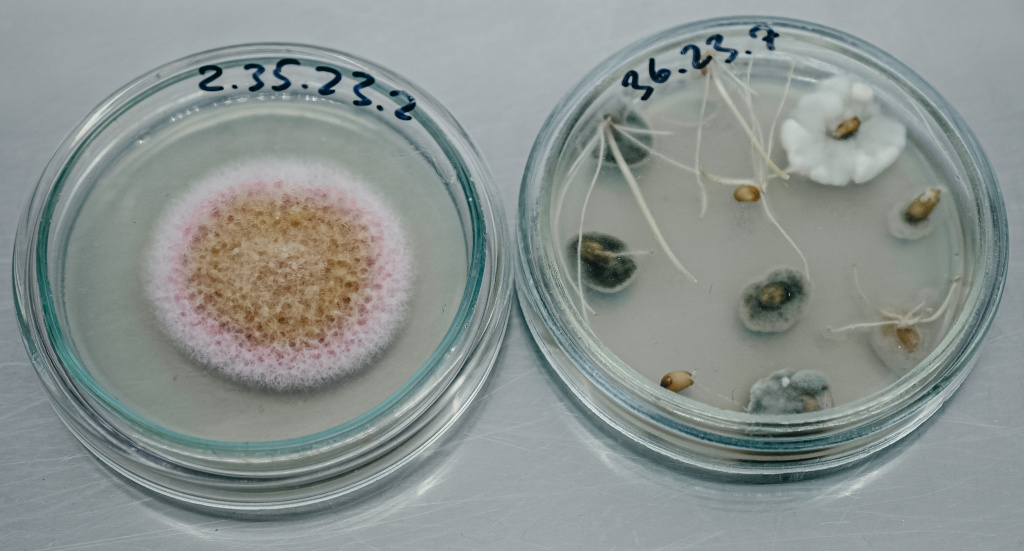
7_ Фузариоз - опасное заболевание пшеницы.jpg

Топ-10 научных кадров 2025 года
20 января 2026 г. ФИЦ КНЦ CO РАН

На Земле нас подстерегает множество угроз. Среди них и невидимые патогены, и токсичные отходы, и смертельные болезни. Миссия ученых — их найти и обезвредить. Предлагаем вашему вниманию 10 кадров 2025 года от научного фотографа специалиста службы научных коммуникаций Красноярского научного центра СО РАН Анастасии Тамаровской, которые показывают, как красноярские ученые используют технологии будущего, чтобы спасти планету и изменить нашу жизнь.
Гриб-разрушитель хвойных деревьев
Ученые Института леса им. В.Н. Сукачева СО РАН впервые обнаружили в Сибири опасный патогенный гриб хвойных пород. Этот вид вызывает некроз сосны. Холодоустойчивый гриб-разрушитель, пришелец из теплых регионов, скрытно готовит захват территорий. Задача ученых — отследить его распространение до начала массового вторжения. Ранее он встречался только в регионах с мягким климатом. Однако исследования показали, что сибирские штаммы гриба устойчивы к холоду и имеют высокую фитопатогенность. Особую опасность представляют завезённые патогены, которые могут скрытно распространяться и не причинять вреда хозяину до тех пор, пока не возникнут благоприятные условия для массовых вспышек заболеваний.

На фото первые секунды реакции биолюминесценции. На ней основана работа нового поколения сенсоров. Это высокочувствительные "светлячки"-белки, настраиваемые под любую задачу. Они светятся, обнаруживая болезнь на самой ранней стадии или помогая создать новое лекарство. Красноярские ученые разрабатывают тесты на рассеянный склероз, рак мочевого пузыря, диабет. Эта технология может стать прорывом для фармацевтики – ключом к новым препаратам и независимости от импорта. Рынок этих технологий стремительно растет. Метод позволит массово производить дешевые и стабильные сенсоры, экспресс-тесты для скорой. Это шанс спасти жизни, ускорить лечение и вывести российские биотехнологии в лидеры.

В биологии и медицине работает очень много женщин. На фото юная участница мастер-класса в НИИ медицинских проблем Севера для будущих генетиков и молекулярных биологов. Она впервые в жизни переоделась в одноразовую спецодежду и попробовала на себе, каково это работать в стерильном боксе. Учитывая острый дефицит кадров в медицине, подобные мастер-классы играют огромную роль в привлечении молодых специалистов.

Чип для раннего обнаружения метастаз
Ученые Красноярского научного центра СО РАН, Красноярского государственного медицинского университета им. проф. В.Ф. Войно-Ясенецкого и специалисты АО «НПП «Радиосвязь» разработали конструкцию миниатюрного проточного чипа с ДНК-аптамерами для выявления опухолевых клеток, циркулирующих в крови. Устройство может стать важным инструментом для ранней диагностики различных видов рака и обнаружения метастаз.

Биопластик из рыбных отходов
Красноярские ученые выделили и идентифицировали бактерию, которая способна с рекордной эффективностью перерабатывать отходы рыбной промышленности в биопластик. Это решает сразу две проблемы: снижение загрязнения окружающей среды и производство «зеленой» альтернативы традиционному пластику. По результатам исследования получен патент на изобретение. Бактерии эффективно перерабатывают более 80% жира, выделенного из отходов кильки и скумбрии, и производят до 70% биоразлагаемого пластика, что значительно эффективнее известных ранее микроорганизмов. Кроме того, ученые могут гибко управлять свойствами получаемого материала. Добавляя в питательную среду различные вещества, они «заставили» бактерий производить разные виды пластика: от высококристалличных термопластов до эластичных резиноподобных сополимеров, что расширяет потенциальную сферу их применения.

Тараканы перерабатывают отходы
Оказывается, тараканы могут быть весьма полезны людям как на Земле, так и в космосе. Они помогают ученым создавать почвоподобный субстрат — плодородную землю из органических отходов. Эта почва подходит для восстановления земель, рекультивации территорий и сельского хозяйства. Особенно это важно для Арктических территорий, которые занимают 30% территории России. Представьте арктический посёлок. Доставка свежих овощей сложна и дорога, а вырастить их на вечной мерзлоте — почти невозможно. Ученые Института биофизики СО РАН работают над технологией, которая сможет обеспечить северян свежей зеленью круглый год, прямо на месте. Это система замкнутого цикла, она превращает органические отходы в ценные ресурсы. В этом процессе участвуют дождевые черви, и разные виды тараканов, которые превращают стерилизованные отходы в ценнейший гумус. Ученые не просто утилизируют мусор. Они создают из него плодородную землю, которая накормит будущие поколения и поможет нашей планете.

Фузариоз — одно из самых опасных заболеваний пшеницы
Ученые Красноярского НИИ сельского хозяйства выводят новые сорта пшеницы, устойчивые к фузариозу — одному из самых опасных заболеваний пшеницы, которое приводит к заражению зерна грибковыми токсинами, что делает его непригодным для потребления. Вспышки заболевания ежегодно фиксируются в различных регионах России. В Красноярском крае зараженность зерна грибом вида Fusarium sporotrichioides, вызывающим фузариоз, достигает 70%. Проблема приобретает особое значение, учитывая сложность борьбы с этим заболеванием. Создание с помощью клеточной биотехнологии устойчивых к этому заболеванию сортов сыграет важную роль в повышении продовольственной безопасности и стабильности сельского хозяйства.
Ученые Института химии и химической технологии СО РАН вместе с международной группой исследователей предложили новую технологию переработки угля. Она позволяет преобразовывать до 97,5% угля в ценное сырье с минимальным количеством отходов и гораздо меньшим содержанием канцерогенного бензопирена. Технология открывает новые перспективы для угольной отрасли, предлагая альтернативу традиционному сжиганию. Полученные материалы могут использоваться для производства углеродного волокна, электродного кокса и других высокотехнологичных продуктов. Технология работает без катализаторов и водорода, в мягких условиях, и позволяет перерабатывать уголь почти полностью. Это делает ее перспективной для замены части нефтяного сырья и развития экологически более чистого производства углеродных материалов

Лидар – это установка по принципу действия похожая на радар. Она предназначена для измерения расстояний, только вместо радиоволны используется волна света. Источник работает на основе импульсного лазерного светодиода. Лидары используются в беспилотном транспорте, для сканирования архитектурных объектов, в роботах-доставщиках, спутниках и даже в метеозондах. Они позволяют точно измерять расстояния и создавать 3D-модели поверхностей. Ученые Института физики им. Л.В Киренского СО РАН совместно с АО «Информационные спутниковые системы» имени академика М.Ф. Решетнёва» разработали лидар, который измеряет расстояние с высокой точностью — от 5 сантиметров до 25 метров.

Магнетизм лежит в основе работы большинства окружающих нас технологий. Благодаря пониманию магнетизма были созданы электродвигатели и генераторы, которые обеспечивают нас электричеством и приводят в движение технику, от метро до стиральных машин. Магниты являются сердцем жёстких дисков и памяти смартфонов и компьютеров, позволяя хранить гигантские объёмы информации. В медицине магнитно-резонансная томография (МРТ) спасает жизни, позволяя заглянуть внутрь человеческого тела без вредного излучения. Сегодня исследования в области магнетизма открывают дорогу к созданию принципиально новых устройств — более энергоэффективной электроники, квантовых компьютеров и сверхчувствительных сенсоров, которые в будущем изменят нашу жизнь так же, как когда-то это сделало обычное электричество.

Поделиться:
